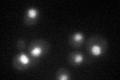
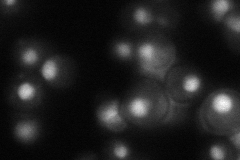
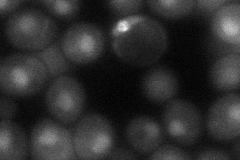

View description
Core Sm protein Sm F; part of heteroheptameric complex (with Smb1p, Smd1p, Smd2p, Smd3p, Sme1p, and Smx2p) that is part of the spliceosomal U1, U2, U4, and U5 snRNPs; homolog of human Sm F
Localization:
Intensity:
Fold change:
Significance:
-
C’ GFP library in SD
nucleus46.44 -
N' NOP1pr-GFP in SD

cytosol,nucleus133.679 -
N' TEF2pr-mCherry in SD

missing0 -
N' NATIVEpr-GFP in SD
nucleus52.5303 -
N' TEF2pr-VC and Cyto-VN in SD
nucleus48.2936 -
C’ GFP library in SD+DTT

nucleus47.461.02No -
C’ GFP library in SD+H2O2

nucleus39.480.85No -
C’ GFP library in Starvation Media

nucleus53.351.14No -
C’ GFP library on the background of Pup2-DaMP

nucleus -
C’ GFP library on the background of CCT mutant

nucleus37.90830.816118No
